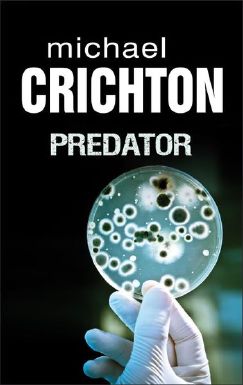

Predator
| Tytuł oryginalny: | Prey |
|---|---|
| Autor: | Michael Crichton (1942-2008) |
| Tłumacz: | Krzysztof Bednarek |
| Wydawcy: | Wydawnictwo Albatros A. Kuryłowicz (2012) Legimi (2012) |
| ISBN: | 978-83-7659-504-7 |
| Autotagi: | dokumenty elektroniczne druk książki powieści proza |
|
|
|
|
|
|
Wypożycz w bibliotece
Kup
Recenzje